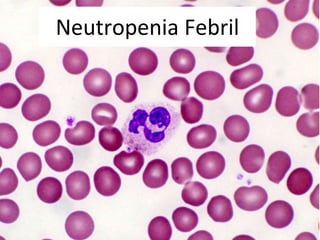
Neutropenia Febril

As três principais emergências oncológicas descritas são:
1) Hipercalcemia, que ocorre em 20-30% dos tumores e causa sintomas metabólicos, musculoesqueléticos e neurológicos graves.
2) Neutropenia febril, definida como febre em pacientes com neutrófilos <500/μL ou previsão de queda para <500/μL, que aumenta o risco de infecções graves.
3) Síndrome de compressão, causada pela invasão direta do tumor ou